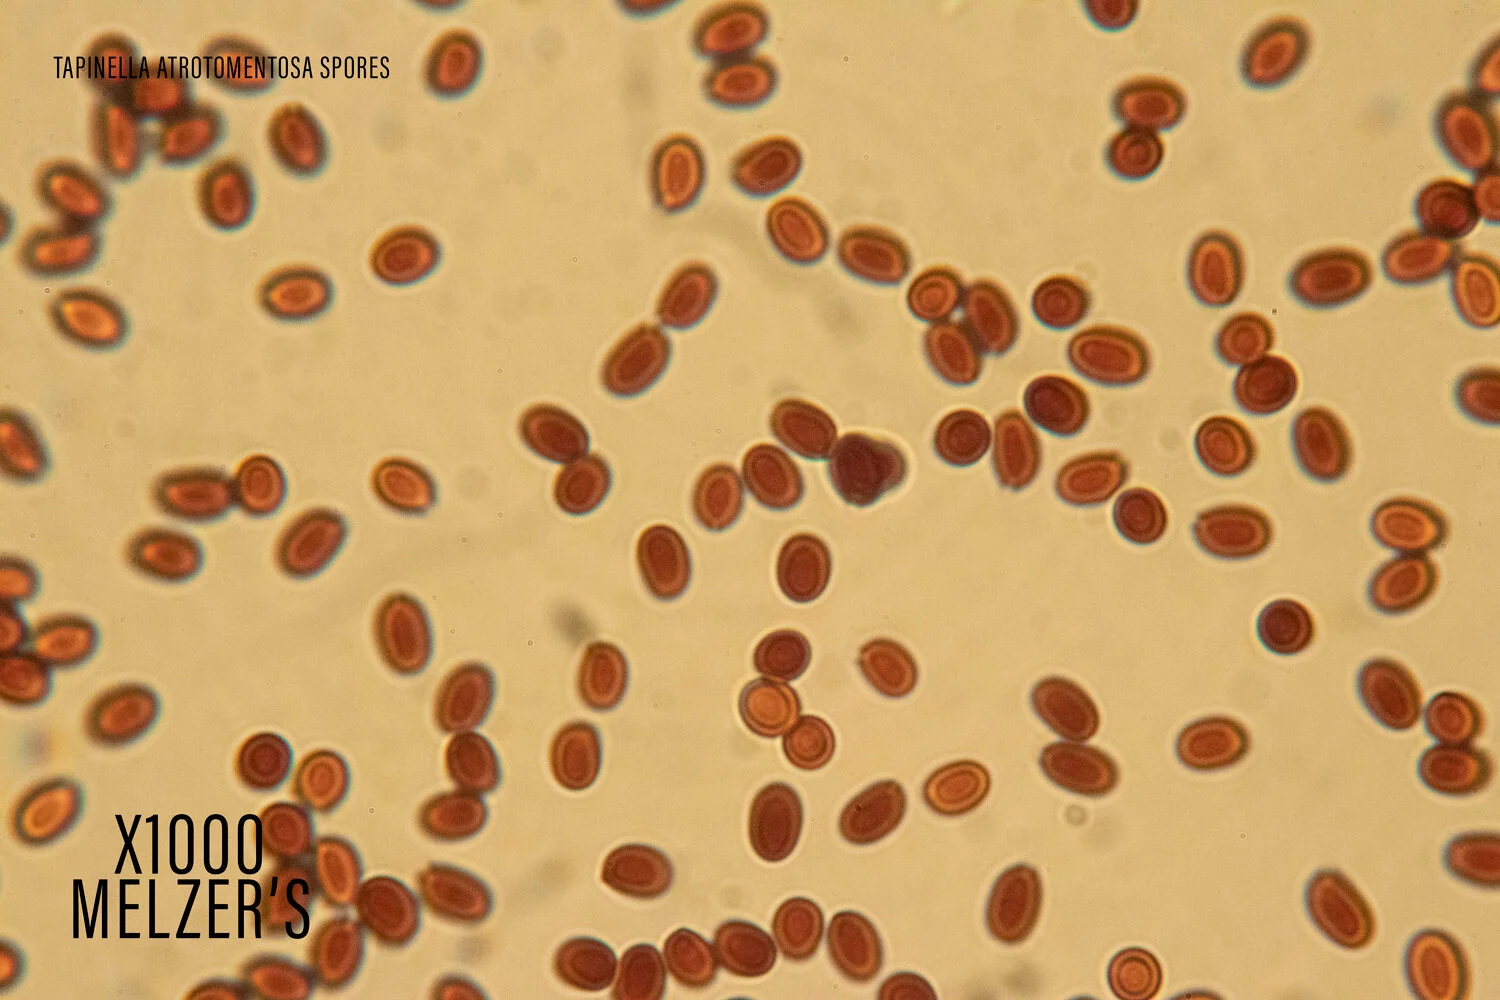

Tapinella atrotomentosa
On July 31st, 2020, I visited the Oregon coast with my friend (and study group partner), Diana, to check on a location we had been just a week earlier. Our goal was to look for the progression of some of the mushrooms we had seen and create some content for our club's mushroom show in November. After a long day of scouting, we discovered the beginnings of the Tapinella atrotomentosa.
This velvety, phallic fruiting body was just pinning, and the stipe (stem of a mushroom) was larger than the cap. The entire surface was a golden brown tomentose (velvet or fuzzy) surface. The cap had a tightly inrolled margin and the gill structure was barely visible. I could see some decurrent (gill structure that runs down the stipe) gill-beginnings, but nothing that would help me key the mushroom to species.
I worked for hours when I got back to my house to try and key the mushroom out. But because I could not get a spore print, or really see the gill structure, I was not able to figure it out. So I decided to use a trick that Jordan, my fellow study group partner, used and do a reverse image search on Google. This worked out really well! My reverse image search brought me to a google result that showed the name of this fuzzy mushroom.
Now that I had a name, it was time to do a little research. I looked up Tapinella atrotomentosa in all of my resources (books, iNaturalist, etc.) and discovered I had indeed found it!
On subsequent forays with my study group, I learned more about this mushroom. Henry, our study group mentor, patiently answered my basic questions, but then was able to tell me some fun facts about this mushroom. He told us that if we put ammonia on the cap of the mushroom, it would turn bright purple. The next week, Diana had gone back to collect a fresh specimen, and in a Safeway parking lot, we decided to experiment. First, we sliced the mushroom in half to reveal the whiteish-yellow flesh. I added one drop of ammonia on the flesh. There was not much of a reaction. So we tried adding a drop to the top of the cap. As soon as that drop hit the cap, it started to turn purple. I am talking- Barney the Dinosaur, bright purple! Diana and I squealed with delight -to the eye-rolls of the non-mushroom fanatic in our party. We watched that reaction for a couple minutes and then decided to test the stipe. This test brought another purple reaction, although not as vibrant as the cap.
On a foray with Jeanie (another member of our study group), Diana and I excitedly told her about the experiment in the parking lot. She later told us that this mushroom was excellent for dyeing fiber and and produced greens in a final product. You can find out more in this blog post.
Over the next 6 weeks, I periodically went back to visit the decomposing tree stump with the group of T. atrotomentosa. There was just one left by the time I went and visited it at the end of September. It had changed so much in 8 weeks. I am so proud that I was able to see the entire progression of this mushroom. It took a long time to mature, and the cap ended up being almost 5 inches in diameter and a flat plane. I thought it looked like a pancake with the cracked brown mature surface.
I was able to get a mature enough specimen at the end of August, and got a yellowish-brown spore deposit. I make all of my spore prints directly on my glass slides, so it is easy for me to collect spores and look at them under the microscope.
I divided the spores on to two different slides so I could do some experiments. I first mounted the slide in DI water and found the broadly elliptical, smooth spores, just as the literature says. I then wanted to see if I got any reactions to Melzer's reagent and ammonia. I normally don't use ammonia in slide mounts, but I wanted to see if there would be a similar purple reaction that we saw when the ammonia was applied to the cap.
While my DI water mounted slide was under the scope, I used a trick Henry taught me. I added a drop of Melzer's to one side of the slide and held a tissue on the opposite side. The absorbent material pulled the water out of the mount and drew the Melzer's across the spores. The spores turned dark reddish brown in Melzer's reagent, so this is a dextrinoid reaction.
I mounted a clean slide with DI water. I wanted to be sure there would be no cross contamination between my chemicals. So with the slide mounted, I used the trick again and added ammonia to the side of the slide and pulled it through with the absorbent material. As the ammonia became more concentrated, a purple hue began to appear on the outside of the spore. Although the entire spore did not react to the ammonia, the outer surface did turn purple!
Tapinella atrotomentosa
Classification:
Fungi
Dikarya
Basidiomycota
Agaricomycotina
Agaricomycetes
Agaricomycetidae
Boletales
Tapinellaceae
Tapinella
Description:
Cap: 5-15 cm diameter, yellow brown to brown, tomentose (fuzzy), inrolled margin when young, then becoming flat and wavy when mature.
Gills: decurrent, blade-like, cream to brown colored, closely spaced and forking
Stipe: about 3 cm thick and stout, tomentose in light brown when young, turning dark brown in age
Flesh: light yellow to brown
Spore print: yellowish-brown
Spores: 6x3 um, broadly elliptical and smooth, inamaloid
No odor
Cap stains bright purple with ammonia!
Immature T. atrotomentosa fruiting on a decaying tree stump on July 31, 2020
T. atrotomentosa on August 27, 2020.
T. atrotomentosa on August 27, 2020.
T. atrotomentosa on September 1, 2020
T. atrotomentosa on September 1, 2020
T. atrotomentosa on September 1, 2020
September 3, 2020 - T. atrotomentosa ammonia experiment added to the cap from the mushroom gathered on 9/1/2020
September 3, 2020 - T. atrotomentosa ammonia experiment added to the stipe from the mushroom gathered on 9/1/2020
The old T. atrotomentosa specimen found on September 27, 2020.
Here are my iNaturalist observations of this mushroom:
https://www.inaturalist.org/observations/55197218
https://www.inaturalist.org/observations/58102386
https://www.inaturalist.org/observations/61190630
Here are the resources I used:
https://www.mushroomexpert.com/tapinella_atrotomentosa.html
https://www.mycobank.org/page/Simple%20names%20search
http://www.speciesfungorum.org/Names/GSDSpecies.asp?RecordID=360246
Siegel, Noah and Christian Schwarz. (2016) Mushrooms of the Redwood Coast: A Comprehensive Guide to the Fungi of Coastal Northern California
Trudell, Steve and Joe Ammirati.(2009) Mushrooms of the Pacific Northwest
Arora, David. (1979) Mushrooms Demystified.